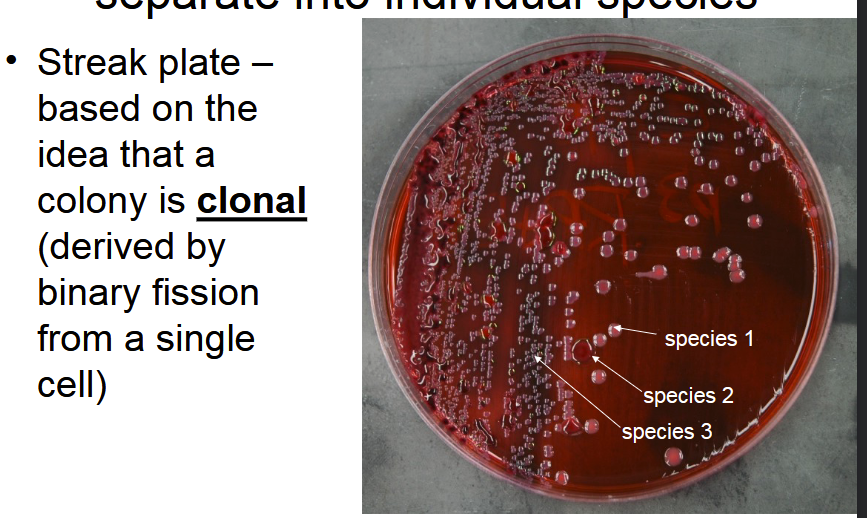
<p>Derived by binary fission from a single cell.</p>
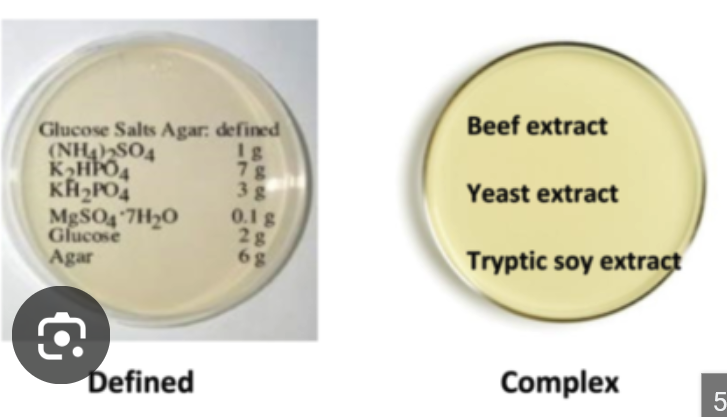
<p>Growth media in which all ingredients can be listed by chemical formula and by amount.</p>
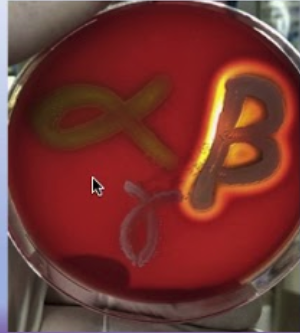
<p>Growth media that cause different organisms to produce different reactions.</p>
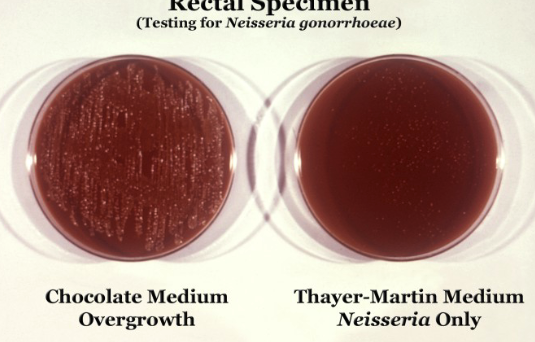
<p>Growth media that prevent the growth of some organisms.</p>

1/84
Looks like no tags are added yet.
Name | Mastery | Learn | Test | Matching | Spaced | Call with Kai |
|---|
No analytics yet
Send a link to your students to track their progress
agar slants
Solid media in tubes with a slanted surface used to store cultures for up to ~1 year.

binary fission
Bacterial cell division process in which a single cell elongates, replicates its chromosome, forms a cross wall, and separates into two daughter cells.

biofilm
A community of microorganisms attached to a surface and embedded in a self-produced extracellular matrix.

clonal
Derived by binary fission from a single cell.
enrichment culture
Specially designed medium that allows one organism to grow better than others and is used to isolate one particular species of organism from a mixed sample.

freezer culture
A pure culture stored in more than 10% glycerol at -70°C (or other cryoprotectant) for long-term preservation.

growth factor
Monomers for each of the biomacromolecules plus vitamins that some bacteria must have provided for growth.
lyophilize
To preserve cells as a pure dry (lyophilized) powder produced by freezing and removal of ice by sublimation. NOT FOR ALL ORGANISMS

nutritionally fastidious
Describes auxotrophic (a mutant microorganism that cannot synthesize a specific, essential nutrient) organisms that must have many growth factors provided.

planktonic
Free-living, single cells not attached in a biofilm.

defined media
Growth media in which all ingredients can be listed by chemical formula and by amount.
complex media
Growth media in which at least one ingredient is not defined and which often contain extracts.

differential media
Growth media that cause different organisms to produce different reactions.
selective media
Growth media that prevent the growth of some organisms.
psychrophile
Group of bacteria with minimum growth temperature below 0°C, optimum 10–15°C, and maximum below 20°C that grow best at relatively low temperature.

mesophile
Group of bacteria with minimum 10–15°C, optimum 30–40°C, and maximum below 45°C; includes most bacteria living in association with warm-blooded animals.

thermophile
Group of bacteria with minimum 45°C, optimum 50–85°C, and maximum above 100°C, showing wide variation in optimum and maximum temperature.

hyperthermophile
Group of bacteria with minimum 65°C, optimum 90–110°C, and maximum 110–121°C, often with optimum above boiling.

acidophile
Bacterium with optimum growth at low pH (approximately pH 1–5).

neutrophile
Bacterium with optimum growth near neutral pH (approximately pH 6–8).

alkalophile
Bacterium with optimum growth at high pH (approximately pH 9–12).

lysis
Cell bursting due to excessive turgor pressure.

osmolarity
The concentration of solutes in the environment that affects water movement across the cell membrane.

plasmolysis
Shrinkage of the cytoplasmic membrane from the cell wall due to water flowing out of the cell in a hyperosmotic environment.

shake tube
Tube of medium used to determine oxygen requirements based on growth distribution in the tube.
fluid thioglycollate medium
Medium used to determine oxygen requirements by providing an oxygen gradient along the depth of the tube.
halophile
Organism that thrives in high-salt environments.
osmoprotectant
Compound such as proline or trehalose synthesized by cells to protect against osmotic stress.
obligate aerobe
Organism showing growth only at the top of the tube where oxygen is high and possessing catalase and superoxide dismutase for oxygen detoxification.

obligate anaerobe
Organism showing growth only at the bottom of the tube where there is no oxygen and generally lacking catalase and superoxide dismutase.

facultative anaerobe
Organism showing growth throughout the tube but thicker at the top and possessing catalase and superoxide dismutase.

microaerophile
Organism showing growth in a thin layer just below the surface and possessing small amounts of catalase and superoxide dismutase.

aerotolerant
Organism showing even growth throughout the tube and possessing superoxide dismutase.

catalase
Enzyme for oxygen detoxification that catalyzes 2H2O2 → 2H2O + O2.
superoxide dismutase
Enzyme for oxygen detoxification that catalyzes 2O2- + 2H+ → O2 + H2O2.
auxotroph
Organism that must have growth factors provided because it cannot synthesize them.
prototroph
Nutritionally robust organism that can make its own growth factors.
chemotroph
Organism that obtains energy from the free energy change of redox reactions.
phototroph
Organism that obtains energy from sunlight via photosynthesis.
lithotroph
Organism that obtains electrons from reduced inorganic compounds.
organotroph
Organism that obtains electrons from reduced organic compounds.
autotroph
Organism that obtains carbon from CO2 (occasionally CO).
heterotroph
Organism that obtains carbon from organic compounds.
Know how bacterial cell division differs from eukaryotic cell division.
By comparing binary fission in bacteria to the eukaryotic cell cycle with G1, S, G2, and M phases.
Describe a biofilm and know the stages of biofilm formation.
By recognizing a biofilm as a community of microorganisms attached to a surface and listing planktonic bacteria, attachment, cell-cell adhesion, proliferation, maturation, and dispersion as the stages.
Explain what it means to say that a bacterial colony is clonal.
By stating that a colony is derived by binary fission from a single cell.
Understand why it is helpful, but not absolutely necessary, to isolate a bacterial colony before studying the growth and physiology of the cells.
By appreciating that single colonies can be used to create pure cultures that simplify analysis of growth and physiology.
Know three ways to store bacterial cultures long-term.
By listing storage on agar slants, as freezer cultures in more than 10% glycerol at -70°C (or other cryoprotectant), and as lyophilized powder.
Know the five categories of bacteria based on optimal growth temperature.
By listing psychrophile, psychrotroph, mesophile, thermophile, and hyperthermophile and their characteristic minimum, optimum, and maximum temperatures.
Be able to sketch a typical graph of bacterial growth rate vs. temp.
By drawing growth rate versus temperature with separate curves labeled for psychrophile, psychrotroph, mesophile, thermophile, and hyperthermophile.
Be able to explain the shape of the graph of bacterial growth rate vs. temp.
By relating the increase and decrease in growth rate with temperature to enzyme activity and protein stability for each temperature group.
Know the five categories of bacteria based on oxygen requirement.
By listing obligate aerobe, facultative anaerobe, obligate anaerobe, microaerophile, and aerotolerant.
Recognize how to distinguish between these 5 types in the laboratory.
By identifying their growth patterns in shake tubes or fluid thioglycollate medium along the oxygen gradient.
Explain the differences in metabolism between the 5 categories based on oxygen requirement.
By explaining which categories use oxygen for respiration, which cannot tolerate oxygen, and which can grow with or without oxygen.
Know the three categories of bacteria based on optimal pH for growth.
By listing acidophile, neutrophile, and alkalophile and their approximate pH optima.
Know two ways in which bacteria prevent plasmolysis in a hyperosmotic environment.
By synthesizing osmoprotectants such as proline and trehalose and by adsorbing salt by binding to protein surface charges.
List 10 elemental nutrients required for bacterial growth.
By listing C, H, O, N, P, S, K+, Mg++, Ca++, and Fe++.
Know where bacteria get these nutrients.
By recognizing that bacteria obtain elemental nutrients from their growth media or environment.
Know what cell structures the nutrients are used to build.
By associating C, H, O with all four macromolecules, N with amino acids and nucleic acids, P with nucleic acids and phospholipids, S with certain amino acids and electron transfer, K+, Mg++, and Ca++ with folding proteins, and Fe++ as the business part of redox proteins.
List the metabolic categories that explain how bacteria obtain carbon, energy and electrons.
By listing chemotroph, phototroph, heterotroph, autotroph, organotroph, and lithotroph.
Be able to categorize a medium as complex or defined based on an ingredients list.
By determining whether all ingredients can be listed by chemical formula and amount or whether at least one ingredient is not defined.
Be able to categorize media as selective or differential based on bacterial growth patterns.
By recognizing whether a medium prevents growth of some organisms or causes different organisms to produce different reactions.
Know how to grow anaerobes, microaerophiles, and obligate parasites in the laboratory.
By growing anaerobes and microaerophiles in an anaerobic (gas-pak) jar or glove box and growing obligate intracellular parasites in tissue cultures or embryonated eggs.
Describe some techniques that have been used to grow bacteria that cannot grow in pure culture.
By using devices such as the iChip multiwell diffusion chamber or microdroplet-microcolony formation to allow interaction with the natural environment while keeping cells separated.
Be able to explain the purpose of an enrichment culture.
By stating that it is used to isolate one particular species of organism from a mixed sample by allowing the organism of interest to grow better than others in specially designed medium.
Know how bacteria divide by binary fission.
By describing chromosome replication, cell growth by lengthening, ingrowth of the envelope, completion of the cross wall, and separation into daughter cells.
Know the major phases of the eukaryotic cell cycle.
By listing G1, S, G2, M, and G0 and their associated checkpoints.

Understand cryoprotectants in preservation.
By explaining that cryoprotectants improve osmotic imbalance and dehydration during slow cooling.
Understand the outcomes of slow and rapid cooling of cells.
By recognizing that slow cooling below 0°C leads to solute injury and cell death and rapid cooling below 0°C leads to ice injury and cell death.
Know the key phase changes of water relevant to lyophilization.
By listing freezing, melting, evaporation, condensation to liquid, sublimation, and condensation to ice.
Understand why oxygen is toxic to some cells.
By stating that reactive forms of oxygen such as O2- and H2O2 oxidize cell materials and must be detoxified by enzymes.
Be able to distinguish oxygen requirements using tube growth patterns.
By matching growth only at the top, throughout but thicker at the top, only at the bottom, in a thin layer below the surface, or evenly throughout to the appropriate oxygen category.
Know the general pH range in which most cells grow.
By recognizing that most cells grow in a range of about 3 pH units and maintain cytoplasm at about pH 7–9.
Understand why cells must avoid lysis and plasmolysis.
By noting that the cell wall retains turgor pressure to prevent lysis and that cells must prevent excessive water loss that leads to plasmolysis.
Know the difference between prototrophs and auxotrophs.
By recognizing that prototrophs can make their own growth factors whereas auxotrophs must have them provided.
Be able to recognize major metabolic lifestyle combinations.
By identifying photolithoautotrophs, chemolithoautotrophs, photoorganoheterotrophs, and chemoorganoheterotrophs based on sources of energy, carbon, and electrons.
Know how defined and complex media differ.
By contrasting media with completely known chemical composition to those with at least one undefined ingredient such as extracts.
Know what is meant by selective and differential media.
By explaining that selective media prevent growth of some organisms and differential media cause visible differences in growth or reactions among organisms.
Understand why some media can be both selective and differential.
By using examples where a medium both restricts which organisms grow and differentiates those that do grow by color change or other reactions.
Know how MSA functions as selective and differential.
By explaining that salt makes only Staphylococcus species grow and that mannitol fermentation by Staphylococcus aureus turns the medium yellow, whereas Staphylococcus epidermidis does not ferment mannitol and Micrococcus luteus does not grow.
Know special culture conditions for anaerobes and microaerophiles.
By growing them in an anaerobic jar or glove box to control oxygen levels.
Know special culture conditions for obligate intracellular parasites.
By growing them in tissue cultures or embryonated eggs instead of standard media.
Understand the concept of “unculturable” bacteria.
By recognizing that more than 95% of bacteria in the environment cannot grow in pure culture and require alternative cultivation approaches.
Know the basic steps of the iChip method.
By capturing one bacterium per well in an environmental sample, enclosing the plate in a breathable membrane, and returning it to the environment so small molecules and metabolites can promote growth.
Know the basic steps of the microdroplet-microcolony method.
By encapsulating individual cells in permeable gel microdroplets, nourishing colonies to 40–200 cells, and separating and plating droplets using flow cytometry.